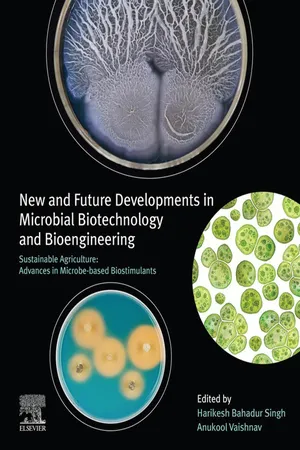

eBook - ePub
New and Future Developments in Microbial Biotechnology and Bioengineering
Sustainable Agriculture: Advances in Microbe-based Biostimulants
- 486 pages
- English
- ePUB (mobile friendly)
- Available on iOS & Android
eBook - ePub
New and Future Developments in Microbial Biotechnology and Bioengineering
Sustainable Agriculture: Advances in Microbe-based Biostimulants
About this book
New and Future Developments in Microbial Biotechnology and Bioengineering: Sustainable Agriculture: Advances in Microbe-Based Biostimulants describes advances in microbial mechanisms involved in crop production and stress alleviation. Recent developments in our understanding of the role of microbes in sustainable agriculture and disease management have created a highly potential research area. The plant holobiont has a significant role in stress signaling, nutrient use efficiency, and soil health and fertility for sustainable developments. The mycorrhizosphere, hyphosphere, phyllosphere, rhizosphere and endosphere are critical interfaces for the exchange of signaling and resources between plants and soil environment.?
This book is an ideal reference source for microbiologists, agrochemists, biotechnologists, biochemists, industrialists, researchers and scientists working on agriculturally important microorganisms and their exploitation in sustainable future applications.
- Gives insights into mechanisms of plant-microbe interaction
- Introduces new aspects and advances in plant-microbe interaction for disease management
- Includes descriptions and modern practices on how to harness the potential of microbes in sustainable agriculture applications
Frequently asked questions
Yes, you can cancel anytime from the Subscription tab in your account settings on the Perlego website. Your subscription will stay active until the end of your current billing period. Learn how to cancel your subscription.
No, books cannot be downloaded as external files, such as PDFs, for use outside of Perlego. However, you can download books within the Perlego app for offline reading on mobile or tablet. Learn more here.
Perlego offers two plans: Essential and Complete
- Essential is ideal for learners and professionals who enjoy exploring a wide range of subjects. Access the Essential Library with 800,000+ trusted titles and best-sellers across business, personal growth, and the humanities. Includes unlimited reading time and Standard Read Aloud voice.
- Complete: Perfect for advanced learners and researchers needing full, unrestricted access. Unlock 1.4M+ books across hundreds of subjects, including academic and specialized titles. The Complete Plan also includes advanced features like Premium Read Aloud and Research Assistant.
We are an online textbook subscription service, where you can get access to an entire online library for less than the price of a single book per month. With over 1 million books across 1000+ topics, we’ve got you covered! Learn more here.
Look out for the read-aloud symbol on your next book to see if you can listen to it. The read-aloud tool reads text aloud for you, highlighting the text as it is being read. You can pause it, speed it up and slow it down. Learn more here.
Yes! You can use the Perlego app on both iOS or Android devices to read anytime, anywhere — even offline. Perfect for commutes or when you’re on the go.
Please note we cannot support devices running on iOS 13 and Android 7 or earlier. Learn more about using the app.
Please note we cannot support devices running on iOS 13 and Android 7 or earlier. Learn more about using the app.
Yes, you can access New and Future Developments in Microbial Biotechnology and Bioengineering by Harikesh Bahadur Singh,Anukool Vaishnav in PDF and/or ePUB format, as well as other popular books in Technology & Engineering & Chemical & Biochemical Engineering. We have over one million books available in our catalogue for you to explore.
Information
Table of contents
- Title of Book
- Cover image
- Title page
- Table of Contents
- Copyright
- Table of Contents
- Contributors
- About the Editors
- Preface
- Chapter 1 Plant growth promoting rhizobacteria - Advances and future prospects
- Chapter 2 Prospects of beneficial microbes as a natural resource for sustainable legumes production under changing climate
- Chapter 3 Trichoderma as biostimulant - a plausible approach to alleviate abiotic stress for intensive production practices
- Chapter 4 Mode of action of different microbial products in plant growth promotion
- Chapter 5 Role of AM fungi in growth promotion of high-value crops
- Chapter 6 Pseudomonas and Bacillus: A biological tool for crop protection
- Chapter 7 Underlying forces of plant microbiome and their effect on plant development
- Chapter 8 Plant viruses as biopesticides
- Chapter 9 Microalgal based biostimulants as alleviator of biotic and abiotic stresses in crop plants
- Chapter 10 Utilization of omics approaches for underpinning plant-microbe interaction
- Chapter 11 Extremophiles for sustainable agriculture
- Chapter 12 Seed biopriming with biopesticide: A key to sustainability of agriculture
- Chapter 13 Insights into novel cell immobilized microbial inoculants
- Chapter 14 Role of mycorrhizosphere as a biostimulant and its impact on plant growth, nutrient uptake and stress management
- Chapter 15 Trichoderma spp. as bio-stimulant: Molecular insights
- Chapter 16 Enhancing the growth and disease suppression ability of Pseudomonas fluorescens
- Chapter 17 Synthetic biology tools: Engineering microbes for biotechnological applications
- Chapter 18 Role of microbial consortia in remediation of soil, water and environmental pollution caused by indiscriminate use of chemicals in agriculture: Opportunities and challenges
- Chapter 19 Sustainable agriculture and viral diseases of plants: An overview
- Chapter 20 Enhancement of plant nutrient uptake by bacterial biostimulants
- Index